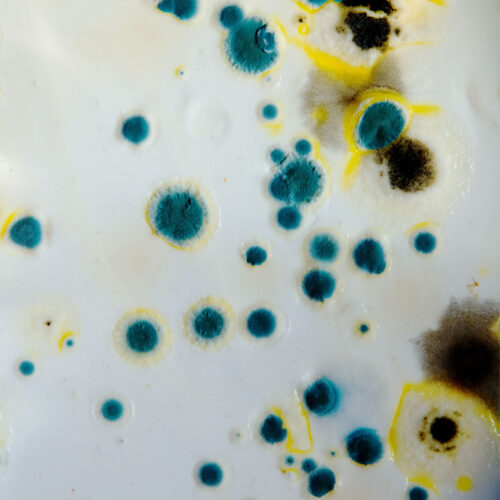

Water Damage Restoration
Immediate water extraction, drying, and structural mitigation to prevent further damage.
read MoreWelcome to Poseidon Restoration, your trusted water mitigation experts in Western Washington.
At Poseidon Restoration, we understand the devastation that water, fire, and mold damage can bring to your home or business. That’s why we’re here to provide expert restoration services to the Puget Sound area and beyond.
As a locally owned and operated company, we take pride in serving our community with dedication, integrity, and a commitment to excellence.
Deliver fast, reliable restoration services while helping clients recover with clarity, confidence, and minimal disruption.
Integrity in every step. Clear communication. Fast response. High standards of workmanship across every project.
Based in Poulsbo, we understand local conditions and respond quickly with solutions tailored to the community.

We lead with compassion and understanding. We support clients through stressful situations with care.
We show up, follow through, and finish the job. You can count on us — always.
We do the right thing, even when no one's watching. Our word is our bond.
We take pride in doing things the right way — with care, precision, and follow-through.
We lead with compassion and understanding. We support clients through stressful situations.
We build people up — our clients, our team, and our community.
We earn trust through honesty, transparency, and action.
Whether you’re dealing with water damage, fire and smoke, or mold, our team handles every step of the process. From emergency mitigation to full reconstruction, we restore your property quickly, safely, and professionally.
24/7 Emergency Response — we act fast when time matters most
Locally Owned & Operated in Poulsbo, WA
Full-Service Company — mitigation and rebuild under one roof
We Work Directly With Insurance Carriers
Clear Communication from Start to Finish
Trained Technicians Following IICRC Standards
Professional, Respectful, and Reliable Team
Not just any restoration company. At Poseidon Restoration, we know the struggle of damage to your home. While you are juggling managing every other aspect of your life, we aim to make the restoration process as simple as possible. Our team of restoration experts work quickly to mitigate further damages and restore your home in its entirety.